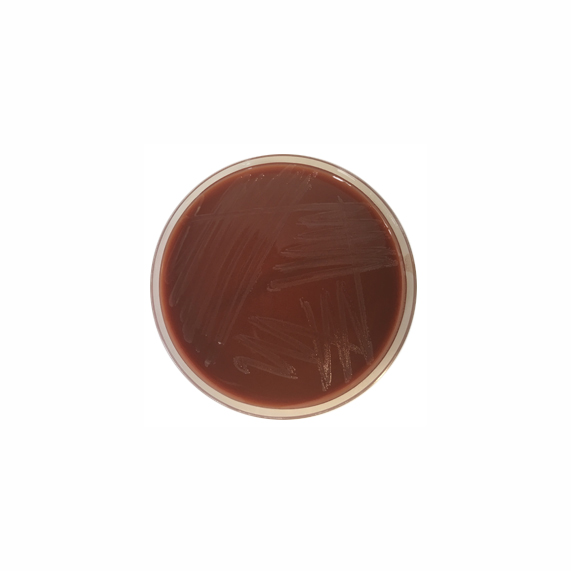
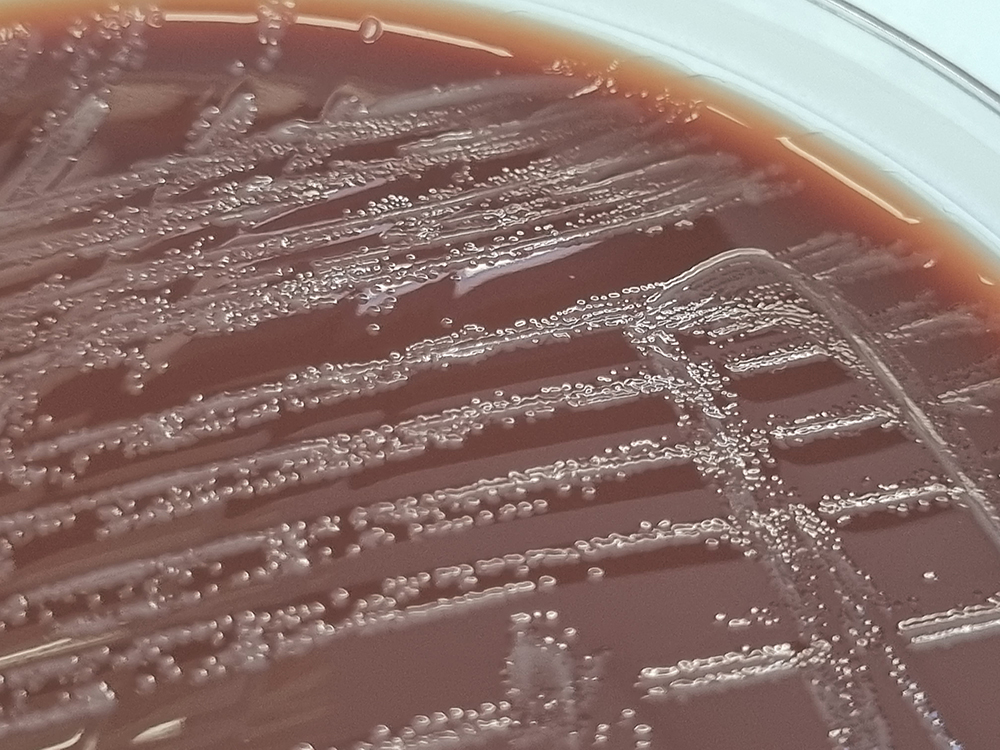

Über das Produkt
Fertigplatten zur Anzucht von Haemophilus spp., Neisseria gonorrhoeae und anderen anspruchsvollen Bakterien.
Schokoladen-Agar mit Polyvitex, Fertigplatten

Fertigplatten zur Anzucht von Haemophilus spp., Neisseria gonorrhoeae und anderen anspruchsvollen Bakterien.